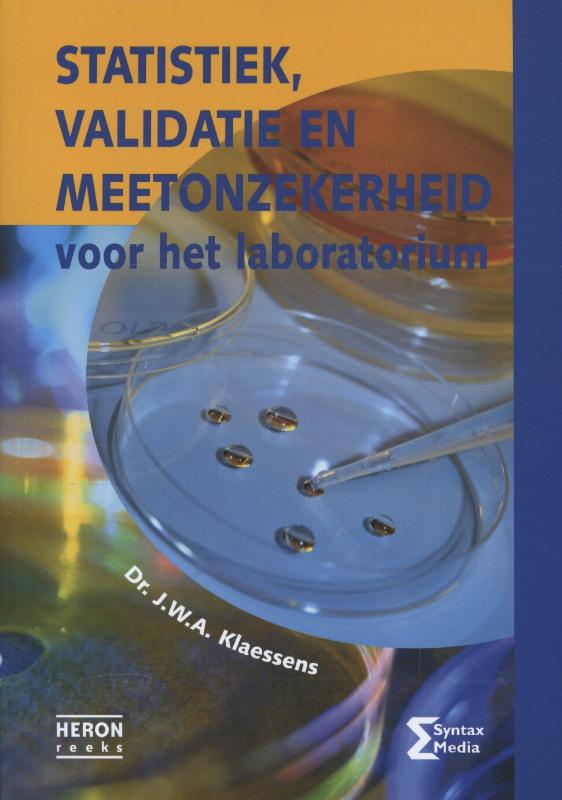
Heron-reeks  -   Statistiek, validatie en meetonzekerheid

Rekenwijzer 1F 2F 3F
Maak tweedehands je eerste keus
- Let op: door stakingen bij BPost in België kan je pakketje later komen.
- 30 dagen retourgarantie
- Gratis verzending vanaf 4 boeken of 40 euro
- Krijg van 21 tot en met 29 juni 10%, 15% of 25% korting per stapel.
- Van 21 tot en met 29 juni 4=3 actie op alles.
nog 1 op voorraad
13,04
ISBN
9789034567529
Bindwijze
Hardcover
Taal
Nederlands
Auteur
Uitgeverij
Uitgeverij Malmberg B.V.
Jaar van uitgifte
2010
Spijtig genoeg zijn er geen recensies over dit boek

Gebruikersondersteuning niveau 3 / MBO-ICT reeks
25% korting
nog 1 op voorraad
11,50
8,62

Rekenblokken hoeveelheden en maten
Tweedehands
Als nieuw
15,60

Servicemanagement MBO ICT niveau 4
25% korting
8,65
6,49

Ontwikkelen en implementeren van informatiesystemen
nog 1 op voorraad
35,00

Servicemanagement niveau 4
Tweedehands
Als nieuw
14,90

Meten en meetkunde / 3F / Leerwerkboek / Taalblokken 3
25% korting
nog 1 op voorraad
9,85
7,39